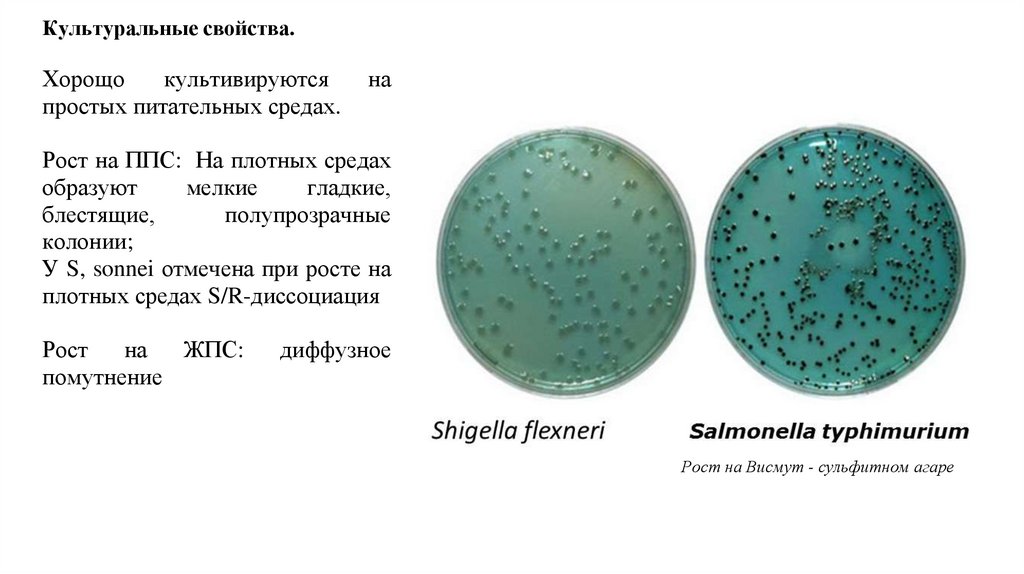

Похожие презентации:
Шигеллы. Клиническая картина
1.
Шигеллы2.
S. dysenteriaeS. flexneri
S. boydii
S. sonnei
3.
Морфология.Неподвижные
палочки
закругленными концами.
Спор и капсул не образуют.
с
4.
Культуральные свойства.Хорощо
культивируются
простых питательных средах.
на
Рост на ППС: На плотных средах
образуют
мелкие
гладкие,
блестящие,
полупрозрачные
колонии;
У S, sonnei отмечена при росте на
плотных средах S/R-диссоциация
Рост
на
ЖПС:
помутнение
диффузное
Рост на Висмут - сульфитном агаре
5.
Биохимическая активность.Слабая биохимическая активность по сравнению с Esherichia и Salmonella.
- отсутствие газообразования при ферментации глюкозы,
- отсутствие продукции сероводорода,
- отсутствие ферментации лактозы в течение 48 ч.
S. sonnei способен ферментировать лактозу медленно, в течение 72 ч.
6.
ФерментацияСубстрат
S. dysenteriae
S.flexneri
S. boydii
S. sonnei
Сахаролитические с -ва.
Глюкоза
К
К
К
К
Лактоза
-
-
-
К (72+ ч)
Маннит
-
К
К
К
Дульцит
-
К/-
К/-
К (18+ ч)
Ксилоза
-
-
К/-
К/-
+/-
+/-
+/-
-
-
-
-
-
Протеолитические с - ва.
Индол
H2S
7.
АГ структураО - АГ.
S. sonnei обладает К - АГ
8.
Факторы патогенности.1) Эндотоксин (ЛПС).
2) Шига-токсин (только у S. dysenteriae 1 серовара)
3) Цитотоксин SLT (Шига - подобные).
4) R - плазмиды
5) Плазмида инвазии (I) детерминирует синтез ipa BCD-инвазинов
9.
Патогенез.10.
Клиническая картина.ИП - 2 - 12 часов, до 2х суток.
Температура до 38
Боли в области живота,
метеоризм
Диарея с примесью крови
Тенезмы
"Ректальный плевок"
Инфекция ограничивается
кишечником
11.
ДиагностикаИсследуемый материал: испражнения
Основной метод - бактериологический.
Для посева отбираются гнойно-слизисто-кровяные образования из средней порции
кала, которые при диагностике заболевания непосредственно высеваются на
лактозосодержащие дифференциальные питательные плотные среды
В случае обнаружения возбудителя посев испражнений обязательно проводится в
селенитовый бульон с последующим вьделением возбудителя на плотных
лактозосодержащих дифференциальных питательных средах.
В качестве вспомогательного метода применяют РНГА
+ Антибиотикограмма
12.
Лечение.Профилактика.
Специфическа:
1) Бактериофаг
нет
2)
Антибиотики
по
результатам Неспецифическая:
антибиотикограммы
- соблюдение санитарно-гигиенических правил
3) Препараты для нормализации микрофлоры - приготовления, хранения и реализации пищевых
(про-,пре-, мета- и другие биотики)
продуктов
- соблюдению правил личной гигиены и других
мероприятий
аналогичных
таковым
при
кишечных инфекциях.

Медицина
Медицина








